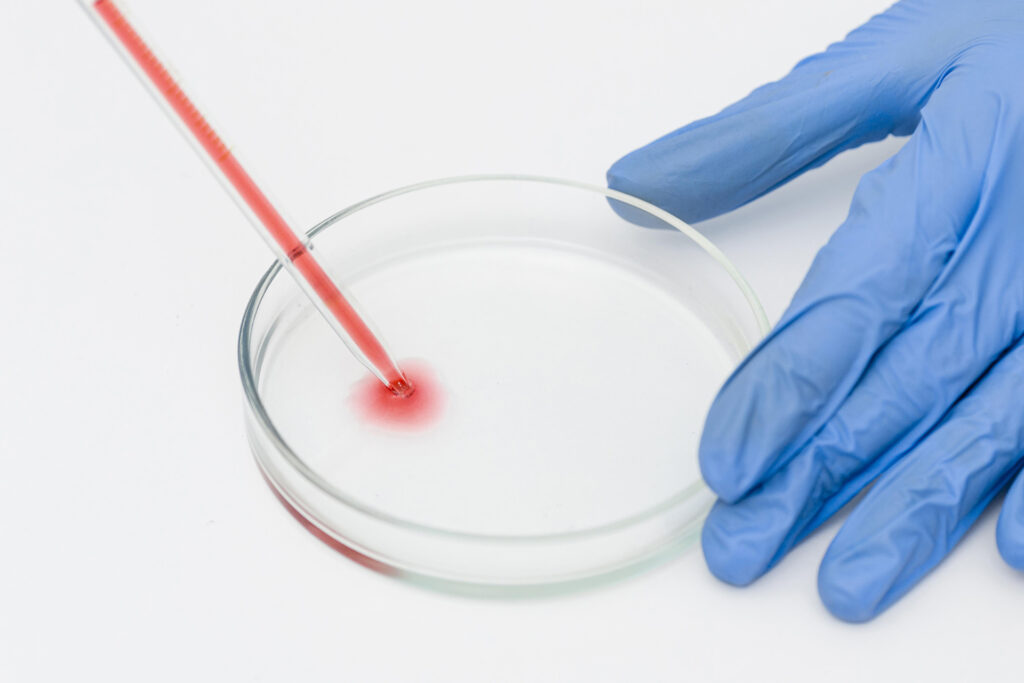

อนุมูลอิสระ” ตัวการร้ายทำลายเซลล์ไข่ สาเหตุสำคัญของภาวะมีบุตรยาก
อนุมูลอิสระ (Free Radicals) หรือ Reactive Oxygen Species (ROS) เป็นปัจจัยสำคัญที่ส่งผลกระทบต่อคุณภาพของเซลล์ในร่างกาย รวมถึงเซลล์ไข่ ซึ่งมีบทบาทสำคัญในการเจริญพันธุ์ของผู้หญิง และยังสัมพันธ์กับอายุที่มากขึ้น ส่งผลกระทบโดยตรงต่อโอกาสในการมีบุตรและภาวะมีบุตรยาก
ครูก้อย นัชชา ลอยชูศักดิ์ ครูวิทยาศาสตร์ผู้ก่อตั้งเพจให้ความรู้เตรียมตั้งครรภ์ยื่นหนึ่งในใจผู้มีบุตรยาก https://www.facebook.com/BabyAndMom.co.th ได้เผยแพร่ความรู้ด้านการเตรียมตั้งครรภ์ตามหลักวิทยาศาสตร์ โดยชี้ให้เห็นถึงผลกระทบของอนุมูลอิสระต่อคุณภาพของเซลล์ไข่ ซึ่งมีความเชื่อมโยงโดยตรงกับภาวะมีบุตรยากผ่านรายการ Research talk EP.22 อนุมูลอิสระทำลายเซลล์ไข่ ส่งผลท้องยาก ทางช่อง YouTube : BabyandMom.co.th
โดยครูก้อย เผยว่า อนุมูลอิสระส่งผลกระทบโดยตรงต่อโอกาสในการมีบุตรโดยอนุมูลอิสระเกิดจากสองปัจจัยหลัก ได้แก่ กระบวนการเผาผลาญภายในเซลล์ของร่างกาย เช่น การเปลี่ยนแปลงอาหารให้กลายเป็นพลังงาน แม้จะเป็นกระบวนการธรรมชาติ แต่อนุมูลอิสระที่เกิดขึ้นสามารถทำลายเซลล์และทำให้ร่างกายเสื่อมถอยได้นอกจากนี้ปัจจัยภายนอกยังเพิ่มการสร้างอนุมูลอิสระ ได้แก่ ความเครียด การนอนหลับไม่เพียงพอ การขาดการออกกำลังกาย และการรับประทานอาหารที่ไม่เหมาะสม เช่น ของหวาน ของมัน หรืออาหารที่อุ่นในไมโครเวฟ รวมถึงมลภาวะที่มีผลต่อการสร้างอนุมูลอิสระ เช่น ฝุ่น PM 2.5 ควันบุหรี่ หรือสาร BPA จากพลาสติก
โดยครูก้อยอธิบายว่าเซลล์ไข่ซึ่งเป็นเซลล์ที่ใหญ่ที่สุดในร่างกายและมีความไวต่ออนุมูลอิสระ หากร่างกายมีปริมาณอนุมูลอิสระสูง จะเพิ่มค่าการอักเสบและส่งผลเสียในหลายด้าน เช่นภาวะไข่ไม่ตกเรื้อรัง หรือถุงน้ำในรังไข่ (PCOS)โรคเยื่อบุโพรงมดลูกเจริญผิดที่การแบ่งตัวของโครโมโซมในเซลล์ไข่ผิดปกติ ทำให้การปฏิสนธิไม่สำเร็จ หรือเกิดการแท้งง่าย รวมถึงความผิดปกติของทารกเช่น โครโมโซมผิดปกติหรือภาวะดาวน์ซินโดรม ซึ่งมักพบในคุณแม่ที่มีอายุมากโดยอนุมูลอิสระเข้าไปทำลายเซลล์ไข่ ทำให้เซลล์ไข่เสื่อมคุณภาพทำให้เซลล์ไข่ฝ่อโดยสร้างความเสียหายต่อ DNA ในกระบวนการแบ่งเซลล์สืบพันธุ์ และทำลายเทโลเมียร์ (Telomere) ซึ่งมีบทบาทสำคัญต่ออายุและสุขภาพของเซลล์ในผู้หญิงที่มีบุตรยาก

“ครูก้อย” อธิบายเพิ่มเติมว่า เมื่อเซลล์ไข่ได้รับผลกระทบจากอนุมูลอิสระจะมีลักษณะบกพร่อง หรือไข่ฝ่อ เช่น ขนาดเล็กกว่าเกณฑ์ (ต่ำกว่า 18 มิลลิเมตร) สีคล้ำ ผิวไม่เรียบ ขาดความยืดหยุ่น และโครงสร้างผิดปกติ ซึ่งทำให้การปฏิสนธิและการพัฒนาของตัวอ่อนมีโอกาสสำเร็จต่ำลง ดังนั้นการลดอนุมูลอิสระในร่างกายจึงเป็นสิ่งสำคัญในการรักษาคุณภาพของเซลล์ไข่และเพิ่มโอกาสในการตั้งครรภ์
อ้างอิงงานวิจัยเรื่อง”Antioxidants Reduce Oxidative Stress in Follicular Fluid of Aged Women Undergoing IVF”ตีพิมพ์ในวารสารReproductive Biology and Endocrinologyปี 2016 ได้ศึกษาผลของสารต้านอนุมูลอิสระต่อการลดความไม่สมดุลของอนุมูลอิสระในของเหลวในถุงหุ้มไข่ (Follicular Fluid: FF) ของสตรีที่มีอายุมากและเข้ารับการทำเด็กหลอดแก้ว (IVF)
ในงานวิจัยนี้ นักวิจัยได้เก็บตัวอย่าง ของเหลวในถุงหุ้มไข่ (Follicular Fluid: FF) จากสตรีมีบุตรยากที่มีอายุมากกว่า 39 ปี ซึ่งเข้ารับกระบวนการกระตุ้นไข่และเก็บไข่ โดยทำการเปรียบเทียบตัวอย่าง ของเหลวในถุงหุ้มไข่ สองรอบการรักษา รอบแรกไม่ได้รับการเสริมวิตามิน ในขณะที่รอบที่สอง ผู้เข้าร่วมได้รับวิตามินและแร่ธาตุที่ช่วยต้านอนุมูลอิสระ (Micronutrients) เป็นระยะเวลาอย่างน้อย 3 เดือน ก่อนการเก็บไข่ ผลการศึกษาพบว่า ในรอบที่ได้รับการเสริม Micronutrients ระดับอนุมูลอิสระในถุงหุ้มไข่ลดลงอย่างมีนัยสำคัญ
“ดังนั้น การเสริมวิตามินและแร่ธาตุที่มีฤทธิ์ต้านอนุมูลอิสระในปริมาณที่เพียงพอก่อนการเก็บไข่ สามารถช่วยลดสภาวะความไม่สมดุลในการเกิดอนุมูลอิสระในของเหลวในถุงหุ้มไข่ (Follicular Fluid: FF) ให้เหมาะสมต่อการพัฒนาของเซลล์ไข่ ซึ่งส่งผลให้ได้เซลล์ไข่ที่สมบูรณ์ขึ้นและพร้อมต่อการปฏิสนธิในกระบวนการทำเด็กหลอดแก้ว” ครูก้อย นัชชา กล่าว
“ครูก้อย”เน้นย้ำถึงความสำคัญของการลดอนุมูลอิสระในร่างกายเพื่อปรับปรุงคุณภาพของเซลล์ไข่ ซึ่งเป็นปัจจัยสำคัญในการเพิ่มโอกาสการตั้งครรภ์และลดความเสี่ยงของภาวะมีบุตรยาก ด้วยการเพิ่มสารต้านอนุมูลอิสระ (Antioxidants) ซึ่งเป็น สารที่ช่วยต่อต้านหรือกำจัดอนุมูลอิสระ (Free Radicals) ที่เกิดขึ้นจากปฏิกิริยาออกซิเดชันภายในร่างกายโดยอาหารที่ให้สารต้านอนุมูลอิสระสูง ได้แก่ ผลไม้ตระกูลเบอร์รี่ ส้ม มะนาว มะกรูด ผักผลไม้ เช่น ผักเคล ผักโขม กะหล่ำม่วง มะเขือเทศ บีทรูท แครอท ทับทิม ธัญพืช เช่น ถั่วต่างๆ งาดำ ควินัว แฟล็กซีด หรือสามารถเสริมสารต้านอนุมูลอิสระในรูปแบบผลิตภัณฑ์เสริมอาหาร ซึ่งเป็นอีกหนึ่งทางเลือกเพื่อเพิ่มความสะดวกในการเสริมสารต้านอนุมูลอิสระแก่ร่างกาย เป็นอีกหนึ่งทางเลือกสุขภาพที่เพิ่มความสะดวกมากยิ่งขึ้น อย่างไรก็ตามผู้บริโภคควรเลือกผลิตภัณฑ์เสริมอาหารที่ได้มาตราฐานการผลิตและน่าเชื่อถือและอ่านฉลากเพื่อศึกษาสารสกัดและส่วนผสมต่างๆ เพื่อความปลอดภัย โดยสามารถติดตามความรู้เกี่ยวกับอนุมูลอิสระที่ส่งผลต่อภาวะเจริญพันธุ์ได้ทางรายการResearch talk EP.22 อนุมูลอิสระทำลายเซลล์ไข่ ส่งผลท้องยาก ทางช่อง YouTube : BabyandMom.co.thหรือคลิกลิงค์ https://www.youtube.com/watch?v=nKLp2vcVWLA&t=1015sหรือแอดไลน์เข้ามาปรึกษาครูก้อยทาง ไลน์แอด :@babyandmom.co.th.

ติดตามเนื้อหาดีๆแบบนี้ได้ที่
Facebook : https://www.facebook.com/innnews.co.th
Twitter : https://twitter.com/innnews
Youtube : https://www.youtube.com/c/INNNEWS_INN
TikTok : https://www.tiktok.com/@inn_news
LINE Official Account : @innnews














